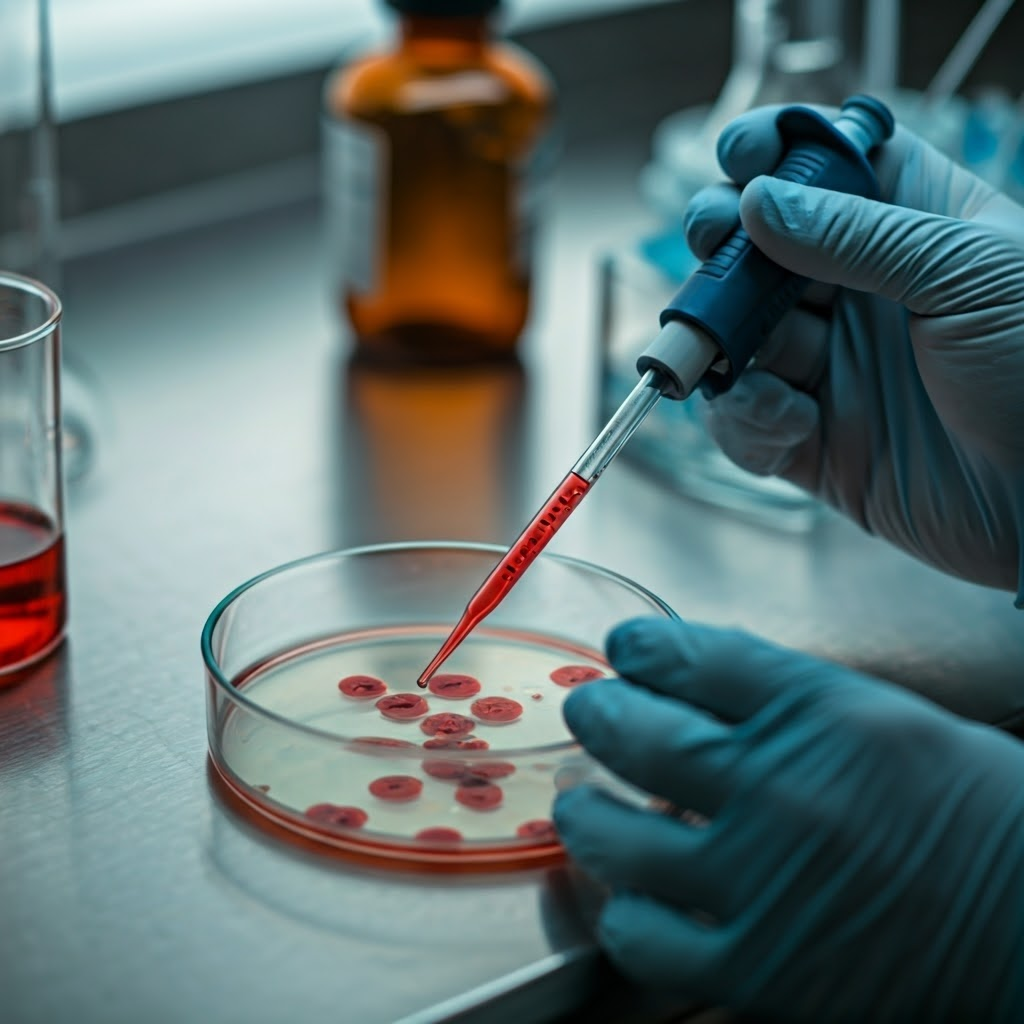
Close-up of a pipette over a petri dish of blood stem cells glowing under lab lights, showing precise ex vivo work

From Petri Dish to Patient: How Gene Editing Gets Real
What Gene Editing Really Means
Gene editing feels like a high-stakes “find and replace.” Instead of fixing a typo on paper, scientists change the DNA that guides how our bodies grow and heal.

The tool everyone talks about is CRISPR. It acts like molecular scissors, finds a chosen spot in DNA, and makes a clean cut. The cell then repairs the break, which can correct, tweak, or delete a faulty gene.

Many illnesses start with tiny genetic errors. One wrong letter causes sickle-cell disease, turning flexible blood cells into painful sickle shapes. Older tools fixed such errors slowly. CRISPR makes edits faster and easier to program, opening the door to practical cures.

Ex Vivo vs In Vivo: Two Ways to Edit Genes
When doctors tackle a genetic problem, they can remove cells, edit them, then return them—called ex vivo—or edit cells directly inside the body, known as in vivo. Think of swapping a car part on a workbench versus fixing it under the hood.
Ex vivo editing suits cells that are easy to collect, such as blood stem cells. Technicians adjust the genes in the lab, test the results, and infuse the best cells back. The process is intense—patients may need chemotherapy—but safety is high because every edited cell is screened first.

In vivo editing demands precise delivery. Scientists load editors into harmless viruses or lipid nanoparticles so they reach the right tissue. Success could mean treatments as simple as an injection, yet off-target edits remain a serious risk.

Sickle-cell disease shows ex vivo success. Teams at UC Berkeley, Vertex, and CRISPR Therapeutics collect stem cells, correct the hemoglobin typo, and transplant them back. The FDA approved this therapy in 2023. Many patients now spend months—sometimes years—free from painful crises, proving gene editing can transform lives.

Leber congenital amaurosis highlights in vivo potential. Editas Medicine injected a CRISPR therapy straight into the retina. Some participants saw shapes and light for the first time. While not a full cure, the trial confirmed that even complex organs can be edited safely inside the body.
Clinical progress is steady but careful. After animal tests, each therapy moves through human trials that watch for benefits and side effects. Every success story shortens the journey from the petri dish to the patient, making once-impossible treatments feel within reach.
